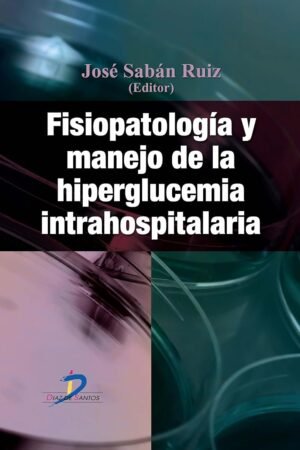
Fisiopatología y manejo de la hiperglucemia intrahospitalaria de José Sabán Ruiz

Salud y medicina
Mostrando 301–400 de 710 resultados
-
El Remedio Homeopático: Lo que la dolencia nos dice de Didier Grandgeorge
Alimentación y Nutrición $99 Añadir al carrito -
El revolucionario mundo de los probióticos: Qué son, cómo funcionan y para qué sirven de Olalla Otero
Alimentación y Nutrición $99 Añadir al carrito -
Elige nutrirte: Una guía consciente para aprender a alimentarte sin hacer dieta de Marcos Bodoque
Alimentación y Nutrición $99 Añadir al carrito -
Enfermé para sanar: Diario Intimo de una victoria de Marina Borensztein
Crecimiento Personal $99 Añadir al carrito -
Esclavos de la comida: ¡Libérate y sé feliz! de Endika Montiel
Alimentación y Nutrición $99 Añadir al carrito -
Estómago Bacterias Digestivas: Los Secretos de las Bacterias que viven en nosotros de Irina Matveikova
Alimentación y Nutrición $99 Añadir al carrito -
Fórmula Va para adelgazar: Bajar de peso o quemar grasa de Dr. Roberto Va
Alimentación y Nutrición $99 Añadir al carrito -
Fundamentos de nutrición y dietética de Leopoldo Vega Franco
Alimentación y Nutrición $99 Añadir al carrito -
Grasas buenas: Cuida tu salud con la nutrición evolutiva de Marc Vergés
Alimentación y Nutrición $99 Añadir al carrito -
Guía fácil para vegetarianos: El camino a la dieta vegana con sentido común de David Roman Molto
Alimentación y Nutrición $99 Añadir al carrito -
Guyton y Hall. Compendio de fisiología médica de John E. Hall
Salud y medicina $119 Añadir al carrito -
Hacer Dieta Engorda: Comer sano para no hacer dieta de Gabriela Uriarte
Alimentación y Nutrición $99 Añadir al carrito -
Hacer fit lo más fat. Las recetas sanas y fáciles de Alberto Ugarte @ugar90
Alimentación y Nutrición $99 Añadir al carrito -
Hambre Emocional: Sana tu sobrepeso con la Descodificación Biológica de Ángeles Wolder
Alimentación y Nutrición $99 Añadir al carrito -
Hipocondría: la ansiedad por la salud de Amparo Belloch Fuster
Salud y medicina $99 Añadir al carrito -
Inteligencia digestiva: Una vision holistica de tu segundo cerebro de Irina Matveikova
Alimentación y Nutrición $99 Añadir al carrito -
Inteligencia nutricional: Aprende a comer de forma saludable de Magda Carlas
Alimentación y Nutrición $99 Añadir al carrito -
Intolerancia a la fructosa: Combatirla sin déficits con una dieta equilibrada de Sonia González
Alimentación y Nutrición $99 Añadir al carrito -
La autolesión en el autismo: ¿Búsqueda o liberación del dolor? de Isabel Paula
Padres y Educación $99 Añadir al carrito -
La biblia de las vitaminas y los suplementos nutricionales de Dominique Rueff
Alimentación y Nutrición $99 Añadir al carrito -
La buena nutrición: La salud empieza en tu lista de la compra de Victoria Lozada
Alimentación y Nutrición $99 Añadir al carrito -
La bulimia me salvó: La historia de trauma, depresión y TCA que nunca quise escribir de Lis Valera
Alimentación y Nutrición $99 Añadir al carrito -
La dieta de las emociones: Encuentra el equilibrio emocional con la alimentación de Neus Elcacho
Alimentación y Nutrición $99 Añadir al carrito